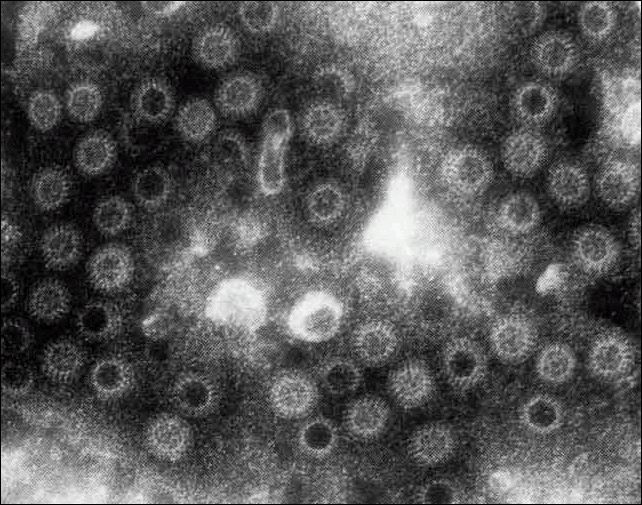

(一)发病原因
轮状病毒属于呼肠病毒科,为双链RNA病毒,直径约为70nm,呈球形。电子显微镜下轮状病毒有独特的形态,如车轮状,故名。其两层外壳包裹着中心的蛋白核心,外层壳体呈轮缘状,环绕核心基因编码蛋白。Vp1~Vp7及五个非结构蛋白(NSPI~4)。单层外壳的颗粒是不完整病毒,没有传染性。
根据衣壳蛋白组特异性抗原Vp6不同,可分为七个血清型(A~G)。儿童感染多为A型所致。而B和C型则主要感染成年人。其他为动物感染的病原体。非A组轮状病毒亦称为不典型轮状病毒或副轮状病毒,感染可见于人、猪、牛、羊、鸡等。
轮状病毒对外界有较强的抵抗力,在室温中可存活7个月,在粪便中可存活数日或数星期。耐酸、耐碱。55℃,加热30min或甲醛可使其灭活。
(二)发病机制
轮状病毒进入体内后能否致病取决于感染病毒的数量、机体免疫状态及机体的生理特征。入侵病毒量多及免疫功能低下时,有助于病毒侵入。机体肠上皮刷状缘的乳糖酶(为轮状病毒受体)含量较多时,如在婴儿时期,则容易感染轮状病毒。随年龄增长,此酶量减少,易感性下降。
轮状病毒进入体内后通过两个途径引起腹泻:一是轮状病毒直接对小肠绒毛上皮细胞损害,引发病理改变;二是轮状病毒在复制过程中的代谢产物作用于小肠内皮细胞,破坏了肠内细胞的正常生理功能引起腹泻。
轮状病毒侵入人体到达小肠后,通过其外壳蛋白Vp4(吸附蛋白)与肠黏膜绒毛上皮细胞上的乳糖酶结合而进入上皮细胞。在上皮细胞质内增生并使其受到破坏、脱落。由于绒毛上皮细胞受到破坏,使乳糖酶等二糖酶减少,导致乳糖向其他单糖转化受阻,乳糖在肠腔内积聚造成小肠及结肠腔内高渗透压,使水分移入肠腔,导致腹泻和呕吐。随后,来自隐窝底部的立方上皮细胞上移、替代已脱落的绒毛上皮细胞,由于其细胞功能未成熟,仍处于高分泌、低吸收状态,结果导致肠液潴留,使腹泻时间延长。轮状病毒复制过程中合成的非结构蛋白NSP4,在轮状病毒致病过程中起肠毒素的作用,可引起细胞内Ca2 水平升高,促使小肠黏膜cAMP水平上升也参与腹泻的形成。如腹泻及呕吐严重,可导致水、电解质紊乱和酸中毒的发生。
本病为可逆性病理改变,黏膜常保持完整性。主要受损部位在小肠。活检可见小肠绒毛缩短而钝,固有层单核细胞浸润,上皮细胞不规则,呈立方形、有空泡或坏死。